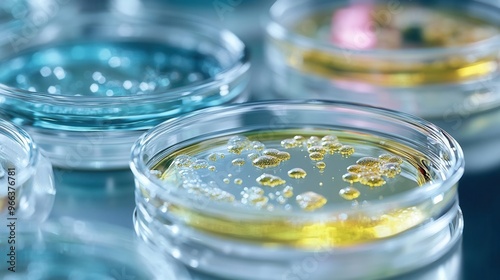

Close-up of colorful petri dishes showcasing vibrant liquid cultures and bubbles in a scientific laboratory setting.
Schlüsselwörter
petri,
culture,
close,
colourful,
dish,
showcase,
vibrant,
liquid,
bubble,
scientific,
process,
technique,
procedure,
study,
design,
method,
organism,
cellular,
outcome,
performance,
structure,
sample,
yellow,
project,
theory,
diet,
surface,
researcher,
monitor